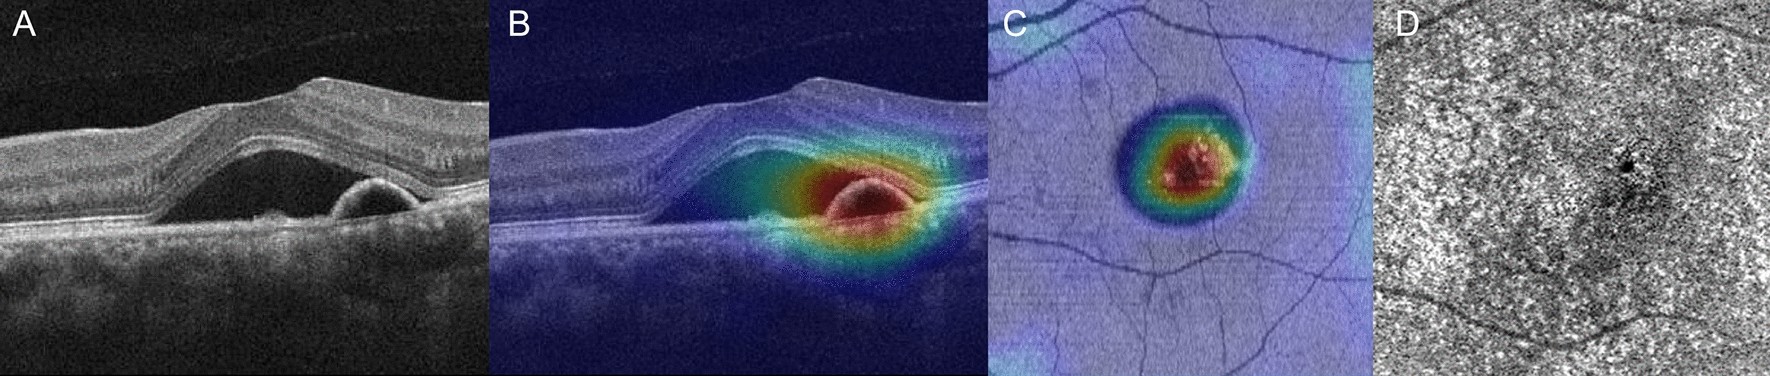
Figure 3

Figure 3
A representative case of persistent CSC with OCT angiography: the left eye of a 45-year-old male. (A) The OCT B-scan shows SRF with shallow irregular PED. (B) The heatmap overlying the OCT B-scan highlights important areas for use of DL in determining the prognosis of this case as persistent CSC. (C) A heatmap overlying the OCT en face image of the ellipsoid zone layer highlights the important areas. (D) OCT angiography does not reveal any choroidal neovascularization.
